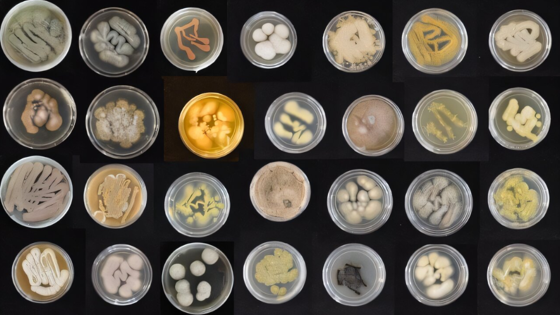

Морские грибы могут перерабатывать пластик в биомассу
Американские ученые протестировали морские грибы на способность перерабатывать пластик. Оказалось, что 42 из 68 организмов могут разлагать полиуретан, использующийся для производства пенопласта и клеев. Всего за 3 месяца некоторые из видов смогли увеличить количество потребляемого пластика на 15%. В будущем организмы могут помочь в очищении окружающей среды и от других материалов, например полиэтилена и полиэтилентерефталата (PET). Исследование опубликовано в журнале Mycologia.Пластик давно стал одной из самых серьезных экологических угроз. Каждый год в океан попадают миллионы тонн пластиковых отходов, которые почти не разлагаются. Под действием солнца и воды они распадаются на микропластики, попадающие в организмы морских животных. Эти частицы накапливаются в пищевых цепях, а химические вещества, содержащиеся в пластике, угрожают экосистемам.Находясь в субтропическом регионе Тихого океана, побережье Гавайев часто становится «конечной остановкой» для пластика, принесенного океанскими течениями. Здесь же находится Большое Тихоокеанское мусорное пятно — огромное скопление пластиковых отходов, размером превышающее несколько стран.Американские ученые решили выяснить, как морские организмы могут перерабатывать пластик. Для этого они собрали образцы грибов с песка, водорослей, кораллов и губок на побережье Гавайев и поместили их в специальные емкости с полиуретаном — синтетическим материалом, использующимся в производстве пенопласта, клеев и гибких изделий. Ученые наблюдали, насколько эффективно грибы «поедают» пластик, выбрали самые продуктивные виды и экспериментальным путем развили их способности, постепенно увеличивая концентрацию полиуретана в среде. Всего исследователи протестировали 68 видов грибов, из которых 42 показали способность перерабатывать полиуретан.«Мы были потрясены, обнаружив, что более 60% грибов, которые мы собрали в океане, обладают той или иной способностью поедать пластик и превращать его в грибы. Мы также были поражены тем, как быстро грибы смогли адаптироваться. Было очень интересно наблюдать, что всего за три месяца, за относительно короткий промежуток времени, некоторые грибы смогли увеличить количество потребляемой ими пищи на целых 15%», — рассказала Ронья Штайнбах, руководитель исследования из Гавайского университета в Маноа, США.Морские грибы продемонстрировали способность не только выживать в экстремальных условиях, но и перерабатывать один из самых сложных для разложения материалов в биомассу. Учитывая их адаптивность, грибы могут стать ключевыми участниками биотехнологий для очистки океанов от пластика.В будущем ученые планируют исследовать, способны ли морские грибы перерабатывать другие виды пластика, например полиэтилен и полиэтилентерефталат (PET). Эти материалы еще сложнее поддаются разложению и являются основными источниками загрязнения. Кроме того, команда намерена понять, как именно грибы разлагают пластик на молекулярном уровне. Эти данные помогут разработать технологии, которые сделают переработку более эффективной.